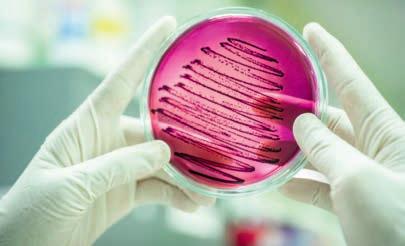

10 minute read
Waste prevention is more efficient than attempts at restoration
by Eurofish
Recent studies have shown promising results regarding the potential of plastic-consuming bacteria in addressing plastic waste in the oceans. However, it is crucial to ascertain the feasibility of this objective rather than viewing it as a mere optimistic notion. Encouragingly, scientists have already identified various strains of bacteria that can effectively decompose specific types of plastic. What is the current state of this research and what is being investigated?
Should we recall the catastrophic explosion of the Deepwater Horizon oil platform in April 2010, which had devastating repercussions on the environment of the Gulf of Mexico? Between April 20th and September 19th of that year, an estimated 700,000 tonnes of crude oil and 500,000 tonnes of natural gas, predominantly greenhouse gas methane, were discharged into the sea before the well was ultimately sealed. is event not only resulted in an environmental crisis but also posed a threat to the climate, as methane is 25 times more detrimental to the climate than CO2 when present in the atmosphere. While attempts were made to disperse the partially burning oil slick using specialized chemicals (according to the US Environmental Protection Agency (EPA), more than seven million liters of these products were sprayed), the gas caused relatively fewer issues. Contrary to the expectations of many experts who had anticipated severe environmental damage for years, this problem seemed to resolve itself. By September the escaping methane gas had almost completely disappeared. is occurrence was attributed to the actions of methane-degrading bacteria, which oxidized the gas and neutralized its harmful e ects. Although methane levels inexplicably dropped drastically after two months, just as suddenly as they had previously increased, it was made clear that microorganisms can be extremely helpful in solving environmental problems in the sea.
Advertisement
Shortly afterwards, scientists succeeded in isolating and scientically describing a new bacterium from oil-contaminated samples from the Deepwater Horizon accident. Despite belonging to the Roseobacter group, one of the most signi cant groups of marine bacteria, this bacterium was assigned to a completely new genus known as Tritonibacter horizontis Tritonibacter demonstrated the ability to utilize sugars, amino acids, and aromatic compounds, such as those found in petroleum, as carbon and energy sources. is unique capability has raised hopes that these bacteria could potentially be utilized in future endeavors to combat oil spills in the ocean. Consequently, the global scienti c community has been actively searching for other types of bacteria with even greater capacities for hydrocarbon degradation in petroleum. is pursuit has yielded fruitful results, as international research teams continue to discover bacteria with similar capabilities. Notable examples include Alcanivorax borkumensis, which converts hydrocarbons into fatty acids and incorporates them directly into its cell membrane and Oleispira Antarctica, which remains e ective even in the frigid temperatures of polar seas. It is important to note that oil-degrading bacteria are not a recent human invention; they have existed for millions of years. e quantities of oil that are introduced into the sea during a disaster are the only man-made components. Marine ecosystems host specialized bacteria, known as marine hydrocarbonoclastic bacteria, which possess the ability to break down aliphatic hydrocarbons and utilize them as an energy source. ese bacteria are present in seawater globally, albeit in limited numbers. However, their population can increase signi cantly upon exposure to crude oil.
The recent discovery of bacteria capable of consuming plastic has sparked optimism
Given the bacteria‘s demonstrated e ectiveness in combating crude oil and gas, it seems logical to explore their application in addressing this urgent problem. It is estimated that approximately 300 million tonnes of plastic currently exist in the oceans, with an additional two truckloads being deposited every minute. e problem: plastics undergo an extremely slow decomposition process. Once introduced into the environment, some persist for several centuries. Due to their complex polymer structure, plastics are composed of lengthy chains of molecules that exhibit resistance to dissolution in water. e resilience of these chains is attributed to their strong bonds. is is primarily in uenced by UV radiation emitted by the sun. is radiation disintegrates the molecular chains and chemical bonds, resulting in a porous material. Wouldn‘t it be advantageous if there were bacteria capable of expediting this process? It is also the case with oil and natural gas. However, the circumstances required for such a phenomenon could not be more distinct. Petroleum is a fossil natural resource that was formed 65 to 200 million years ago when dead marine animals and plants sank to the bottom of the sea and did not decompose completely due to the lack of oxygen. As a result, microorganisms had many millions of years of evolution to develop abilities to utilize these food and energy sources. Plastics, on the other hand, have only been around for a few decades. at is an extremely short period of time for evolutionary development processes! Consequently, many scientists have expressed skepticism regarding the existence of bacteria capable of breaking down and recycling plastic. eir astonishment was even greater when Japanese biochemists discovered bacteria with a plastic-destroying enzyme in a recycling plant in 2016. e bacterium called Ideonella sakaiensis 201-F6 is able to metabolise the plastic PET (polyethylene terephthalate) to meet its energy needs. Sakaiensis must have acquired this ability within a few decades, because PET has only been produced in large quantities since the 1950s. Unfortunately, Ideonella bacteria are extremely slow and therefore hardly suitable for the ght against plastic waste. It took the bacterium an impressive six weeks to completely decompose a 20 mm long and 15 mm wide strip of plastic lm. However, the discovery of the plastic-eating bacterial species excited scientists around the world and triggered a real boom in research projects. Just two years later, a US-British research team achieved signi cantly faster decomposition of PET by making a small molecular change to the enzyme. But even that is far from enough to achieve clearly measurable results in the ght against plastic waste in the oceans.
An abundance of different materials becomes a problem
In addition, PET is just one plastic among many others from the group of thermoplastic synthetic resins. Around 90 percent of global plastic production comes from the following six materials (in order of frequency): polyethylene (PE), polypropylene (PP), polyvinyl chloride (PVC), polystyrene (PS), polyurethane (PU/ PUR) and polyethylene terephthalate (PET). e latter, PET, is primarily used for drink bottles and accounts for around 18 of global plastic waste. Nevertheless, many recycling e orts worldwide are focused on this plastic because PET is chemically more easily degradable than polyethylene, polypropylene or PVC. Unfortunately, there is currently no practical solution for these signi cant “mass plastics”. However, there is a promising solution for polystyrene, commonly known as Styrofoam, as bacteria have been discovered in the intestines of mealworms that may be suitable for its degradation. It seems particularly di cult to nd microbes that break down polyurethane, which is used in foam mattresses, household sponges and even sneakers. and Landscape Research have identi ed microorganisms in the Graubünden Alps and the Arctic that can e ectively break down two types of plastic, namely biobased polyurethane (PUR) and fossil-based butylene adipate-coterephthalate-polylactide (PBAT/ PLA), which is commonly found in compostable plastic bags. What is particularly noteworthy about this discovery is that plastic degradation can occur at relatively low temperatures, thereby potentially reducing the cost of implementing technical solutions. e plastic-eating bacteria also include the species Rhodococcus ruber and the widespread bacterium Comamonas testosteroni. contribute to the natural recycling of plastic, as this bacterium possesses a natural a nity for biodegradable plastics. However, speci c conditions must be met for this process to occur, as the physical properties of most plastics make it exceptionally challenging for bacteria and their enzymes to degrade the material. e molecules within the structure of PET and other plastics are so densely packed that they o er minimal “accessible surfaces” for the enzymes to act upon. Conversely, loose or porous structures are more amenable, as they provide greater opportunities for enzymatic degradation.
Regardless of the small successes achieved, each new discovery allows researchers to delve deeper into the subject and gain a better understanding of how bacteria attack plastics and which enzymes are suitable for this purpose. A research team at the University of Hamburg has identi ed several hundred enzymes, known as PET hydrolases that have the ability to degrade plastic.
Above all, they all basically break down the PET very slowly. However, some types of bacteria even seem to prefer plastic material in water to their natural food. Studies on 29 European lakes showed that these bacteria grow faster on plastic than on natural substrates such as leaves and twigs. Some scientists even speculate that the proliferation of bacteria on plastic particles could potentially impact the aquatic food chains, as they serve as a high-energy food source for larger organisms like waterfowl and sh. e discovery that plastic pollution can stimulate ecological interactions within a lake is a highly curious revelation.
Nevertheless, based on the promising research ndings of recent years, it can be inferred that there are signi cantly more microorganisms in the environment that biologically attack and break down plastics than previously believed. In fact, over 18,000 plastic-consuming enzymes have been discovered in soil alone, with approximately 12,000 found in the sea. However, the ultimate e ectiveness and e ciency of these enzymes remain largely unknown. Almost all the ndings to date were obtained under optimized laboratory conditions at constant temperatures with a good supply of nutrients. is makes it quite di cult to transfer the results directly to nature, because the conditions there are quite unstable and vary over time and space.
Scientists from the Swiss Federal Institute for Forest, Snow
According to a study published in the Marine Pollution Bulletin, Rhodococcus could digest nearly 1 of plastic in the oceans into CO2 each year and thus removing it from the water. Comamonas also has the potential to eir limitations in nature may be harnessed for technical purposes, such as in bioreactors designed for plastic upcycling. In such systems, bacteria can be provided with optimal conditions for growth. Initial practical experiments have already been conducted, including those involving Pseudomonas bacteria. ey swim in a “soup” of shredded, chemically treated plastic mixed with water. ey feel extremely comfortable in this substrate and break down the plastic into molecules that can be used as building blocks for new synthetic materials, such as adhesives. e concept under consideration has not yet been implemented on an industrial scale, however, it appears to be equally e ective as the “Poliloop” concept. A French start-up has developed a bacterial cocktail that can process plastic into a sludgy mass resembling compost made from fruit or vegetable waste, free from any toxic residues, within a period of approximately eight weeks. e French start-up, known as Carbios, has progressed further and intends to establish a bacterial PET recycling plant on a commercial scale by 2024. More speci cally, Carbios uses a bacterial enzyme to fully recycle PET bottles. Allegedly, the plastic is “inde nitely recyclable” with this process. is would be a signi cant step forward, as recycled plastics have generally been considered inferior and are only used for niche products. e catch, however, is that the recycled Carbios plastic will initially be more expensive than newly synthesized plastic. e success of this project, therefore, hinges on consumers‘ willingness to pay more for more sustainable packaging.
Society‘s acceptance also in uences another innovative process, as bacterial enzymes can now be genetically modi ed to break down plastic PET at an unprecedented rate. With the enzyme mutation FASTPETase, bacteria can accomplish in a few days what takes several centuries in nature, and at relatively low temperatures of around 50°C! is research is currently in its preliminary stages, however, the potential implications for environmental remediation are intriguing. e utilization of genetically modied bacteria could prove to be a valuable asset in the cleansing of plastic-contaminated regions and bodies of water. Nonetheless, this approach would only be feasible in isolated facilities where microorganisms are completely contained, as has been the standard practice in the biotechnology industry for some time. Genetically modi ed organisms must not be packed into normal sewage treatment plants and certainly not released into the open sea. e safety risk would be far too great. It cannot be ruled out that these “mutants” could also attack plastic sports and leisure boats. However, the situation is di erent in isolated systems without environmental contact; the use of genetically modi ed bacteria to break down plastic might be possible here. Of course, public acceptance of this approach is crucial.

It is our responsibility to address the issue of plastic waste ourselves, and as such, we are faced with a decision-making dilemma. Despite the existence of plasticeating bacteria in nature, their slow rate of action makes it unlikely that they can single-handedly solve the problem of plastic pollution. e release of genetically modied bacteria into the environment is not a viable option due to the incalculable risks associated with it. e image of bacteria e ortlessly consuming vast amounts of plastic waste in land lls and oceans is a fallacy. On the other hand, the rst possibilities are emerging—albeit tentatively—of perhaps solving the problem with technical methods or at least gradually reducing it. However, this would be expensive, because wastewater treatment plants for plastic degradation are likely to be costly, especially if genetically modi ed bacteria are used. e logistics of collecting, sorting, and transporting large quantities of plastic waste to the bacteria would also pose a signicant challenge. is is a bad business model as products generated from the process have little value. It is more expensive to repair environmental damage than to prevent it. erefore, the question remains whether humanity is willing to make the necessary e ort and nancial investment to eliminate plastic waste.
Currently, we are limited to a single option: to expand the mechanical recycling systems and make them more e cient. is endeavor requires signi cant e ort and substantial nancial investment. In cases where batches are contaminated with food or incompatible materials, disposal is often the only viable solution, typically through thermal methods such as incineration. It is estimated that a mere tenth of plastic waste is actually recycled on a global scale. e term “recycling” is no more than a euphemism to alleviate our guilt, as worldwide, an excessive amount of plastic is discarded into the environment, rendering it nearly impossible for us to take action. e notion that plasticconsuming bacteria equipped with “super enzymes” could alleviate the burden of cleaning up our oceans and resolving the immense plastic crisis is highly unlikely and merely serves as a distraction from the true challenge at hand. Ultimately, the only e ective solution lies in minimizing plastic waste and ensuring its prevention from entering the environment and oceans in the rst place. Manfred Klinkhardt
Estonia’s fishing sector bears the hallmarks of a digital nation




